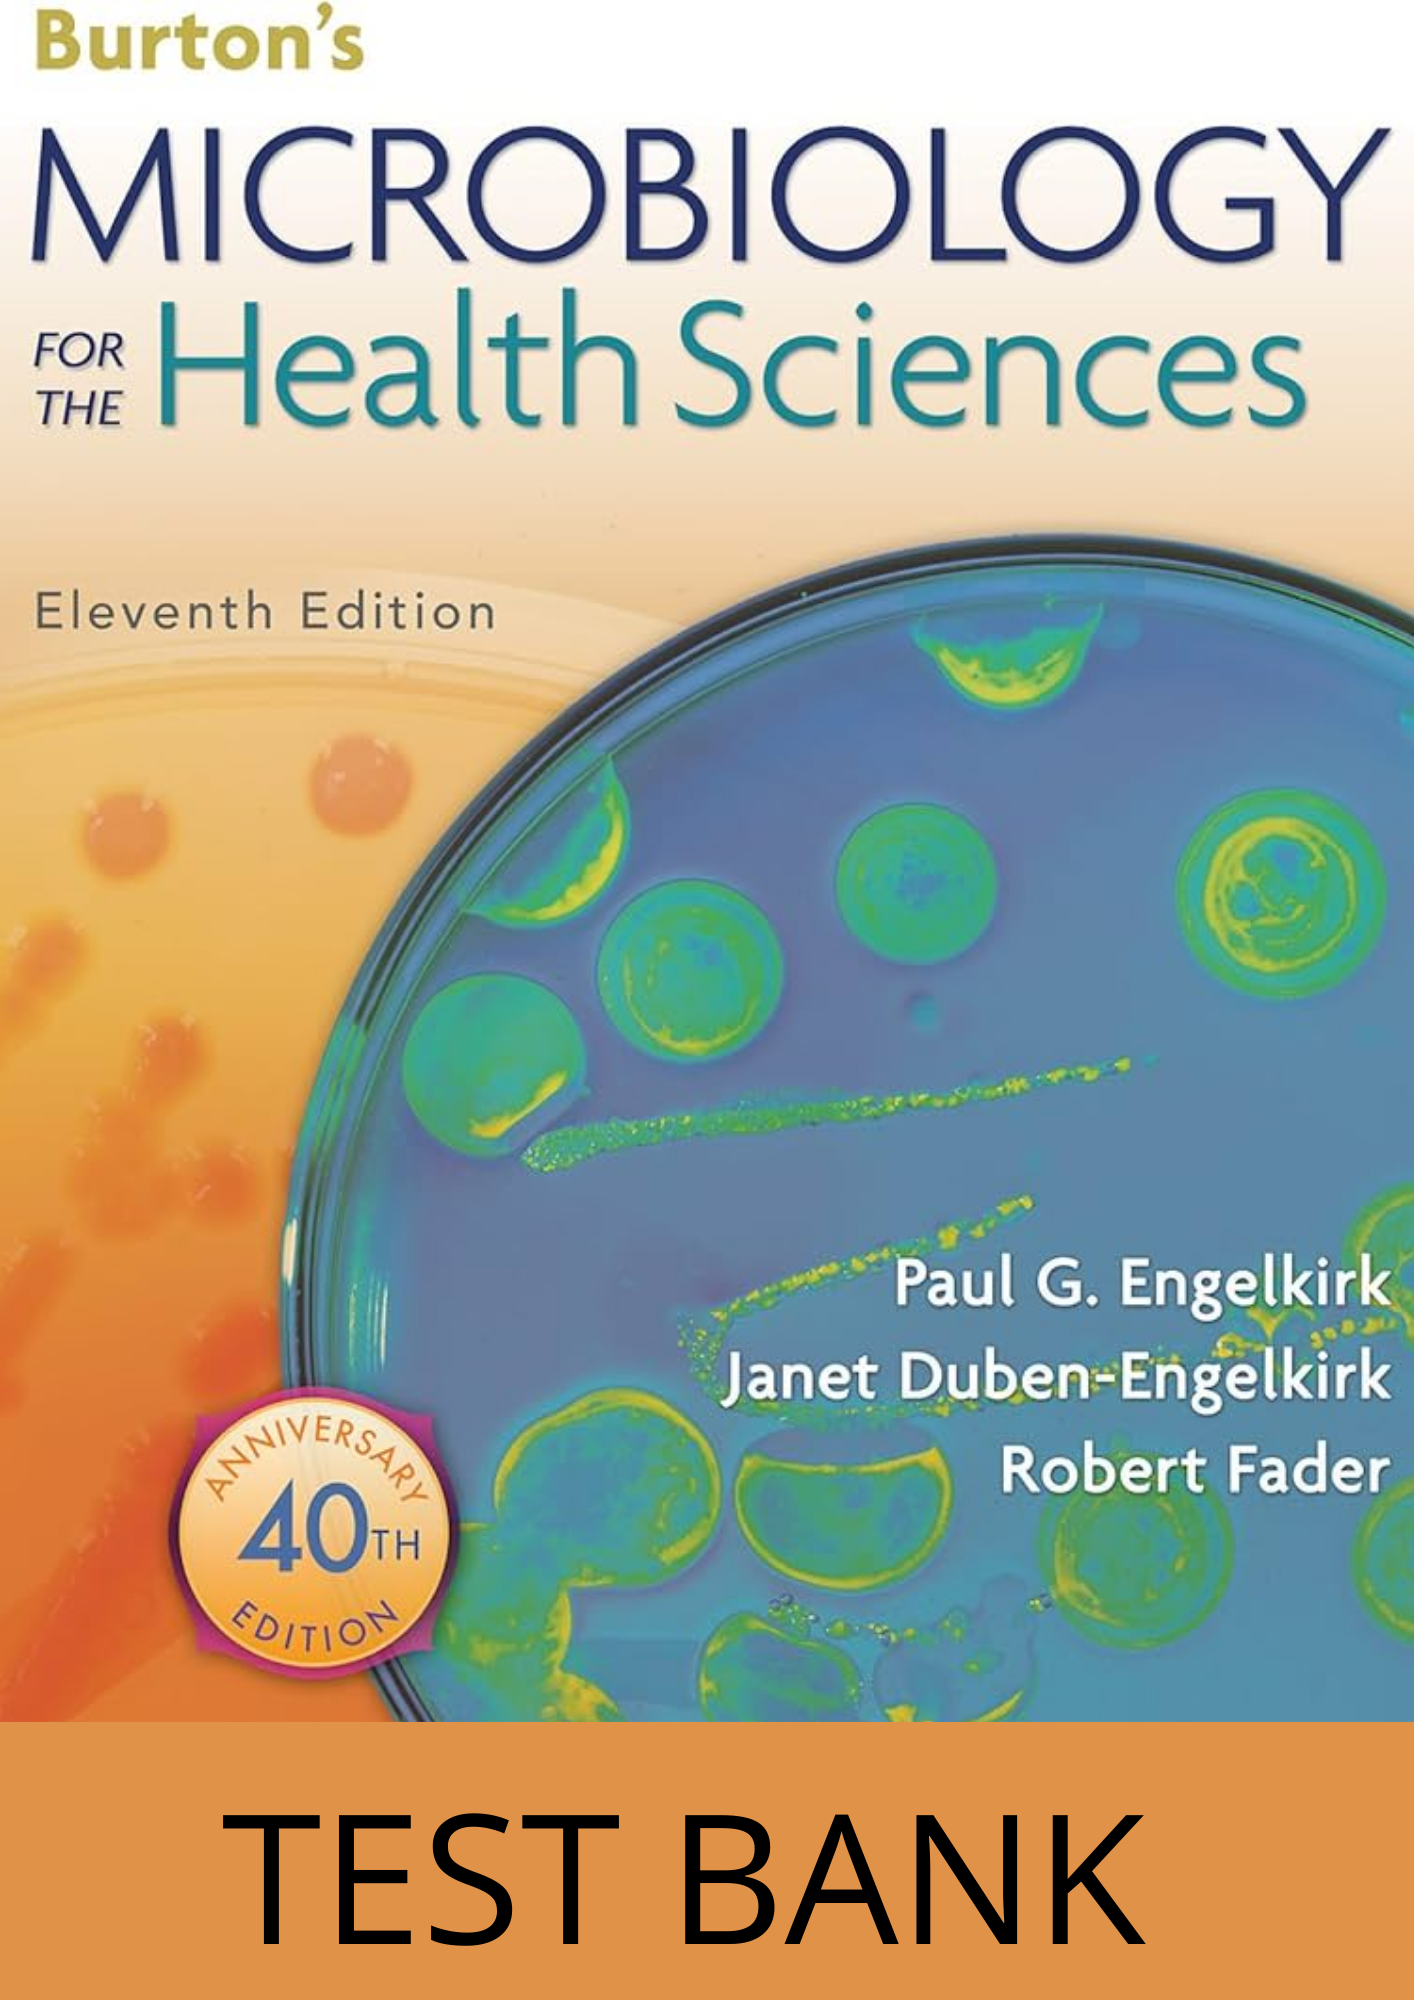

Welcome to the world of test banks – your key to academic success. Find comprehensive, expertly curated resources that enhance your study experience. Access our extensive collection spanning various subjects and courses, designed to help you excel in your studies. Achieve your educational goals confidently with the support of our high-quality test banks. Explore the path to academic excellence with us.
You can access the file instantly after checkout. An alternate download link will also be sent to you via email. If you do not receive the access within 15 minutes, please contact us at **support@olytest.com** or use the **Contact Us** page to request a new link.
Reviews
There are no reviews yet.